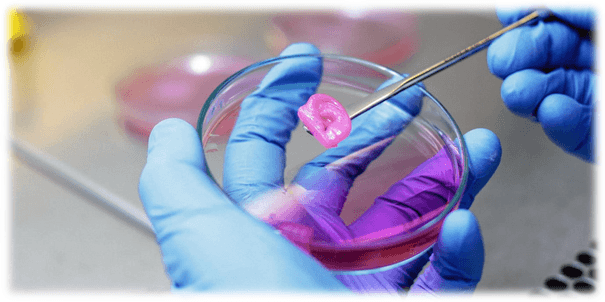
Doku Mühendisliği: Geleceğin Tıbbını İnşa Etmek

Yapay Zeka: Geleceğin Sihirli Dönüşümü
Teknoloji dünyasında sessizce başlayan ve hayatımızın merkezine yerleşen devrim.

Teknoloji dünyasında sessizce başlayan ve hayatımızın merkezine yerleşen devrim.

Sosyal medya bizleri nasıl etkiliyor?

E-kitap hakkında kısa bir bilgilendirme.

Teknoloji ilerledikçe artan asosyallik duygusunu anlamak ve gerçek bağlantıların önemini vurgulamak

Hiç çok kızdığınız için bir içeriğe yorum attığınız ve paylaştığınız oldu mu? Öfke yemini yutmuş olabilirsiniz.

The future is much closer...

Dijital çağın sanatsal devrimi..

Dijital mahremiyetin ve veri güvenliğinin hayatımızda ne kadar önemli olduğunu biliyor musunuz?

Yeni nesil gerilla reklam olabilir mi?

Doku mühendisliği, hasarlı dokuları onarmak veya yeni organlar oluşturmak için vücudun kendini yenileme gücünden yararlanan bir bilimdir.

The evolution of digital photography: Shrinking devices, fast and practical applications and recreations.
İnternet bağımlılığının negatif sonucu olan e hastalıklar nelerdir?